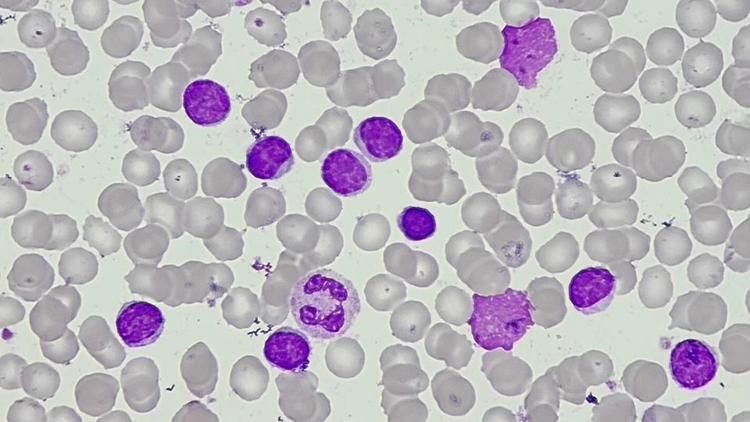
ANS incorpora ibrutinibe associado a venetoclax para LLC em primeira linha

Clínica Médica
30 agosto 2024|

Clínica Médica
29 agosto 2024|
Hematologia
28 agosto 2024|

Clínica Médica
28 agosto 2024|

Hematologia
24 julho 2024|

Hematologia
23 julho 2024|

Clínica Médica
08 julho 2024|

Clínica Médica
08 julho 2024|

Hematologia
6 novembro 2024|4 min.

Ginecologia e Obstetrícia
23 setembro 2025|5 min.

Hematologia
19 abril 2022|7 min.

Endocrinologia
29 maio 2024|4 min.